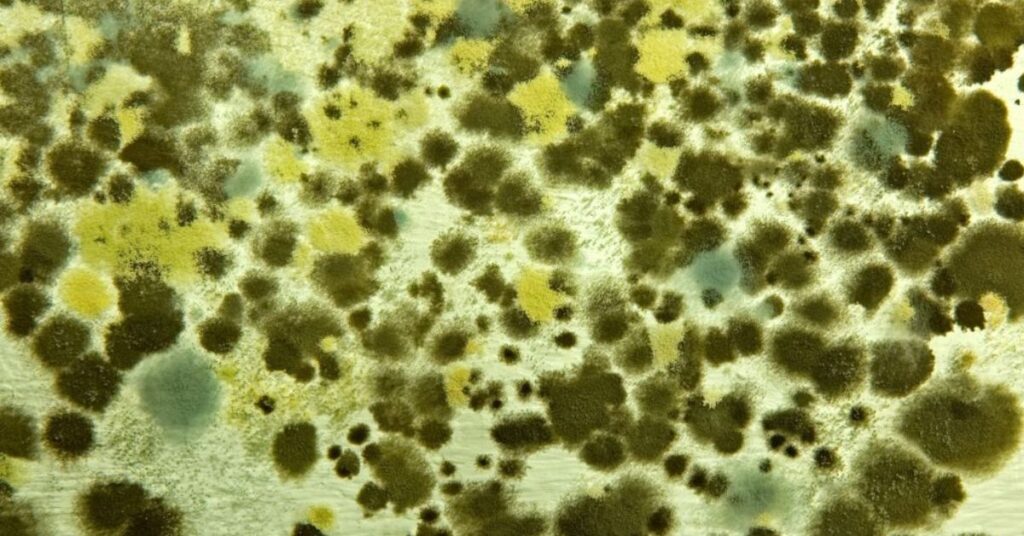

The Ultimate Guide to Shower Cleaning & Maintenance | Rust, Mold, Tiles, Glass & More
Your shower is supposed to be a sanctuary—a place to wash away the day’s stress and grime. But when that […]
The Ultimate Guide to Shower Cleaning & Maintenance | Rust, Mold, Tiles, Glass & More Read Post »